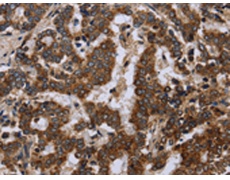
一抗

|
Background: |
The balance between fission and fusion regulates the morphology of mitochondria. TTC11 is a component of a mitochondrial complex that promotes mitochondrial fission (James et al., 2003 [PubMed 12783892]). |
|
Applications: |
ELISA, WB, IHC |
|
Name of antibody: |
FIS1 |
|
Immunogen: |
Fusion protein of human FIS1 |
|
Full name: |
fission, mitochondrial 1 |
|
Synonyms: |
TTC11; CGI-135 |
|
SwissProt: |
Q9Y3D6 |
|
ELISA Recommended dilution: |
2000-5000 |
|
IHC positive control: |
Human liver cancer and Human brain |
|
IHC Recommend dilution: |
25-100 |
|
WB Predicted band size: |
17 kDa |
|
WB Positive control: |
Raji cells, mouse liver and heart tissue |
|
WB Recommended dilution: |
500-2000 |


 購物車
購物車 幫助
幫助
 021-54845833/15800441009
021-54845833/15800441009